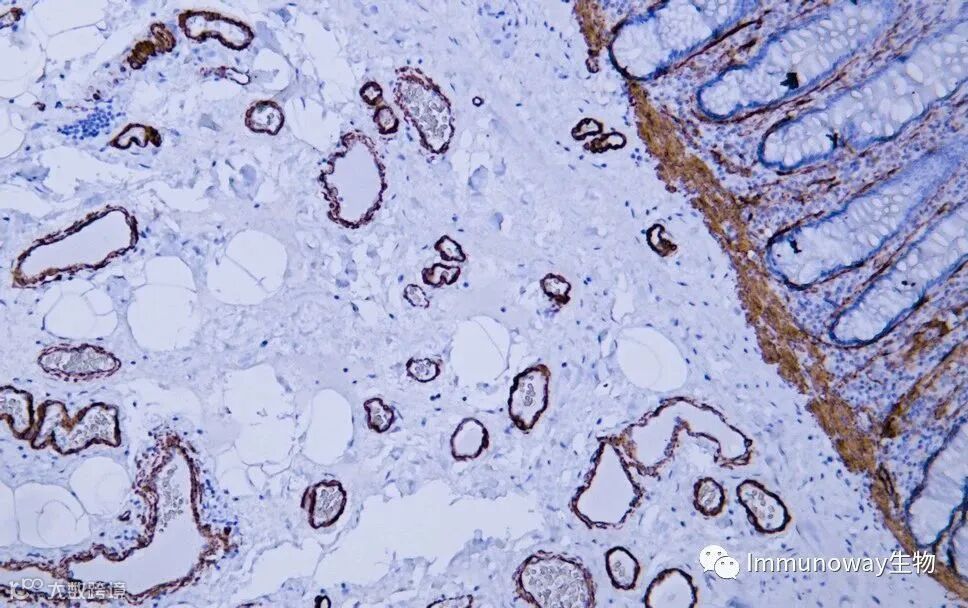

Immunoway为您提供俱全二抗1000+,高品质,覆盖多种属,多类型,拥有多标记,满足多种应用需求。

特异性强,灵敏度高,低背景,高稀释比,最高可达1:5000-20000。
种类齐全1000+;
覆盖多种属,一抗来源于Bovine,Cat,Chicken,Dog,Donkey,Duck,Goat,GuineaPig,Horse,Human,Monkey,mouse,Pig,Rabbit,Rat,Sheep....均有对应二抗可选择;
覆盖针对同一种属来源抗体不同的类别,分型和片段;
多种标记,如HRP,Alexa Fluor系列,Dylight系列,FITC,AU,BIOTIN等供选择;
满足多种实验需求,如WB,IHC-p,Elisa,IF/ICC,FCM等。

DOI:10.1016/j.cell.2022.03.044
(IF 41.58)
HRP*Monoclonal mouse Anti Monkey IgG(RS030204),ELISA应用。

DOI:10.1038/s41423-022-00906-w
(IF 22)
Dylight 800, Goat Anti Mouse IgG (RS23910),WB应用。
Dylight 800, Goat Anti Rabbit IgG (RS23920),WB应用。

DOI: 10.1016/j.cej.2022.135712
(IF 13.2)
Goat Anti Rabbit IgG (H&L) - Alexa Fluor 488 (RS3211),IF应用。

DOI: 10.1038/s41467-022-33656-4
(IF 17.6)
HRP* Goat Anti Mouse IgG(H+L) (RS0001),WB应用。
HRP* Goat Anti Rabbit IgG(H+L)(RS0002),WB应用。

活动时间:2024.12.19(周四)上午十点开始。
步骤1:
扫描上方二维码,关注Immunoway生物
步骤2:公众号平台回复关键词“immunoway”,即可参与抽奖
本期礼品:京东卡;HRP* Goat Anti Mouse IgG(H+L)(RS0001)50ul;HRP* Goat Anti Rabbit IgG(H+L)(RS0002)50ul。
领奖:
礼品抽完即截止。中奖后请填写收件信息,信息统计后会由Immunoway当地授权代理伙伴统一派发礼品,10个工作日左右派发。
提示:
本活动仅限生命科学与医学领域单位、科研院所及院校科研工作者、老师及在研学生参加,Immunoway当地授权代理商伙伴配送范围予以兑奖,感谢大家的关注。
- END -
About
关于睿捷生物科技有限公司
睿捷生物科技有限公司是 (realgen-bio Co., Ltd.,简称睿捷生物)致力于为国内生命科学领域提供先进、专业的仪器设备、试剂耗材的企业。公司目前是近20家国际知名生物公司的一级代理商,为客户提供从研发到生产的各类实验室仪器,检测试剂和生产设备。
公司产品领域涵盖分子生物学、免疫学、血液学、肿瘤研究、信号通路、药物筛选、干细胞研究、神经生物学、表观遗传学等等,为用户提供系统性的科学研究完整解决方案,成为众多研究者们可以信赖的选择。
公司成立于2011年,总部位于苏州,在南京、济南、合肥都设有办事处,公司客户主要为国内领先的生物制药、细胞治疗、生物医学和各类生物技术公司,以及大量的生命科学基础研究和政府实验室,目前已服务客户单位5000余家。


睿捷-企业文化
公司的使命:高效服务客户、为客户持续创造价值
公司的愿景:将人与科技相结合,成为生命科学领域一流的解决方案供应商。
公司的价值观:诚信、公开、坚持、分享
睿捷-合作伙伴



